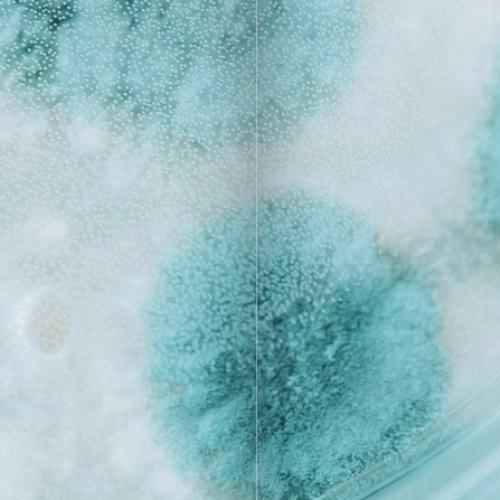

Microbiologie et chaîne alimentaire
Le département MICA développe des recherches en microbiologie fondamentale et appliquée focalisées sur l'alimentation, la santé animale et humaine et les biotechnologies.
PRESENTATION
Le département MICA a pour objets d’étude les microorganismes (bactéries, phages, levures, champignons, microalgues), qu’ils soient en lien avec les aliments, associés aux animaux et aux êtres humains ou utilisés en biotechnologies et bioraffineries environnementales. Ses objectifs de recherche sont de comprendre le fonctionnement et d'améliorer la gestion et la valorisation des microorganismes et des écosystèmes microbiens. Les résultats obtenus contribuent à l’amélioration de la qualité et de la sécurité sanitaire des aliments, au bien-être et à la santé des animaux et de l’être humain, ainsi qu'au développement de la microbiologie pour l'utilisation non-alimentaire de la biomasse et des effluents et déchets de la chaîne alimentaire.
Vous trouverez ci-dessous plus d'informations sur nos recherches, nos structures et nos impacts sociétaux.
Notre actualité
Les chiffres-clés
Les équipes :
- 26 unités (dont 16 en cotutelle avec d’autres départements INRAE et 19 en cotutelle avec d'autres organismes de recherche et d'enseignement supérieur)
- 343 titulaires INRAE (dont 41% chercheurs, 22% ingénieurs, 37% techniciens).
- > 1327 titulaires d’autres départements INRAE et d’autres organismes
- ~250 contractuels, doctorants et post-doctorants
Les moyens :
- Budget de fonctionnement du département : 2,5 M€
- Budget annuel total : 40,8 M€ salaires inclus (73%) dont 12,3 M€ de ressources contractuelles
- 13 dispositifs scientifiques collectifs stratégiques (plateformes, collections de ressources génétiques, démonstrateurs préindustriels, infrastructures scientifiques collectives)
Les résultats :
- ~370 publications annuelles dans des revues scientifiques à comité de lecture, en moyenne de 2016 à 2021
- 130 déclarations d'invention et résultats valorisables de 2016 à 2022
- plus de 70 brevets déposés de 2016 à 2022
- 5 start-up issues d'unités MICA entre 2016 et 2022
Nos événements
Plus d'informations sur...
OFFRES D'EMPLOI ET DE STAGES
Contactez le département MICA










